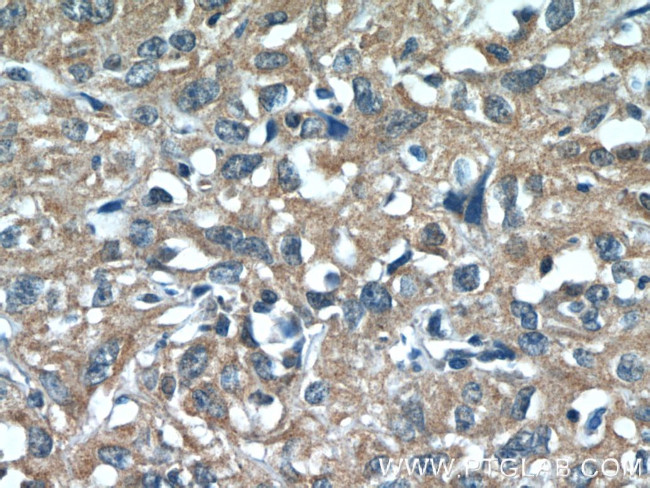
N4BP3 Antibody in Immunohistochemistry (Paraffin) (IHC (P))
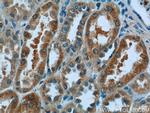
N4BP3 Antibody in Immunohistochemistry (Paraffin) (IHC (P))

Search
Proteintech
N4BP3 Polyclonal Antibody
{{$productOrderCtrl.translations['antibody.pdp.commerceCard.promotion.promotions']}}
{{$productOrderCtrl.translations['antibody.pdp.commerceCard.promotion.viewpromo']}}
{{$productOrderCtrl.translations['antibody.pdp.commerceCard.promotion.promocode']}}: {{promo.promoCode}} {{promo.promoTitle}} {{promo.promoDescription}}. {{$productOrderCtrl.translations['antibody.pdp.commerceCard.promotion.learnmore']}}
产品信息
16733-1-AP
种属反应
宿主/亚型
分类
类型
抗原
偶联物
形式
浓度
规格
纯化类型
保存液
内含物
保存条件
运输条件
产品详细信息
This antibody detects 60 kDa N4BP3 protein and a weaker 40 kDa protein.
Immunogen sequence: GRSPGTGPS PFSSSLGHLN HLGGSLDRAS QGPKEAGPPA VLSCLPEPPP PYEFSCSSAE EMGAVLPETC EELKRGLGDE DGSNPFTQVL EERQRLWLAE LKRLYVERLH EVTQKAERSE RNLQLQLFMA QQEQRRLRKE LRAQQGLAPE PRAPGTLPEA DPSARPEEEA RWEVCQKTAE ISLLKQQLRE AQAELAQKLA EIFSLKTQLR GSRAQAQAQD AELVRLREAV RSLQEQAPRE EAPGSCETDD CKSRGLLGEA GGSEARDSAE QLRAELLQER LRGQEQALRF EQERRTWQEE KERVLRYQRE IQGGYMDMYR RNQALEQELR ALREPPTPWS PRLESSKI (198-544 aa encoded by BC053323)
靶标信息
N4BP3, also named as KIAA0341, a Fezzin family member, during nerve cell development. It is crucial for axonal and dendritic branching in developing neurons. It binds the protein NEDD4 and interacts with 14-3-3 proteins. N4BP3 is present in early neurites, growth cones, axons and dendrites of developing primary hippocampal neurons.
仅用于科研。不用于诊断过程。未经明确授权不得转售。
生物信息学
蛋白别名: KIAA0341; N4BP3; N4BP3 {ECO:0000250|UniProtKB:O15049}; N4bp3 {ECO:0000312|RGD:1308356}; Nedd4 binding protein 3; nedd4 binding protein 3 {ECO:0000312|EMBL:ABA06436.1}; NEDD4-binding protein 3; unnamed protein product
基因别名: C330016O10Rik; KIAA0341; LZTS4; N4BP3; RGD1308356
UniProt ID: (Human) O15049, (Rat) Q3LUD3, (Mouse) Q8C7U1
Entrez Gene ID: (Human) 23138, (Rat) 303112, (Mouse) 212706